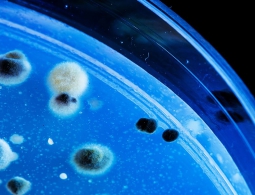
Создан препарат, заставляющий опасные бактерии разрушать собственную ДНК

Ученые: рак груди грозит каждой десятой женщине в России
Специалисты из медико-генетического центра Genotek заявляют, что геном примерно 11% российских женщин содержит в себе хотя бы одну мутацию, повышающую шансы на развитие рака груди и яичников, сообщает пресс-служба компании."Мы провели это исследование не для т...
Открытие малой планеты за Нептуном поставило под сомнение «девятую планету»
С тех пор как появилась возможность того, что на орбите Солнца где-то за Нептуном может кружиться большая девятая планета, астрономы были заняты ее поисками. Одна из групп изучает четыре новых движущихся объекта, найденные представителями общественности, чтобы увидеть, могут ли они быть новыми...
Ученые выяснили, какие черты лица больше всего зависят от генов
Сравнение трехмерных слепков лица близнецов помогло британским ученым выяснить, что гены больше всего влияют на форму кончика носа, размеры скул, уголки глаз и области вокруг губ, говорится в статье, опубликованной в журнале Scientific Reports."То, что гены влияют н...
Успех миссии Breakthrough Starshot к Проксиме b может быть важнее, чем мы думаем
Планета Проксима b, которая находится в одной из самых близких к нам звездных систем, стала достижимой целью проекта Breakthrough Starshot. Мы не знаем, покажет ли этот «звездный выстрел» планету, пригодную для заселения людьми, но он определенно необходим нам для освоения наше...
Почему существуют пределы того, что могут прогнозировать физики?
Если делить вещество во Вселенной на все меньшие и меньшие составляющие, вы в конечном итоге достигнете ограничения, столкнувшись с фундаментальной и неделимой частицей. Все макроскопические объекты можно поделить на молекулы, даже атомы, затем электроны (которые фундаментальны) и ядра, затем на про...
Российские математики доказали осмысленность манускрипта Войнича
Ученые из Института прикладной математики имени М.В. Келдыша РАН, проведя статистические исследования, убедились в том, что текст манускрипта Войнича написан на двух смешанных языках с исключением гласных букв.До этого все попытки расшифровать уникальный документ и даже...
Учёные открыли новый жуткий вид моллюсков
Открытие новых видов животных – это всегда очень интересное и важное для науки событие. Учёные уверены, что в будущем их ждёт множество невероятных сюрпризов, которые природа по сей день скрывала от человечества. Взять хотя бы вот это удивительное червеобразное существо, на...
Создано изображение «универсального отпечатка пальца», способное обмануть большинство сенсоров
Сканеры отпечатков пальцев уже давно не новинка на рынке мобильной электроники. Они в первую очередь призваны обеспечивать дополнительную безопасность пользовательских данных, но 100% гарантии от несанкционированного проникновения, естественно, дать не могут. А недавно группа исследователей из униве...
Создан препарат, заставляющий опасные бактерии разрушать собственную ДНК
Устойчивость некоторых видов болезнетворных бактерий к существующим антибиотикам повышается с каждым годом. Учёные из разных стран пытаются придумать универсальное лекарство, к которому бы бактерии не привыкали так быстро, но пока это никому не удалось. Однако некоторые исследования выгляд...
10 величайших научных открытий и достижений последнего десятилетия
За последние 10 лет в мире науки произошло немало удивительных открытий и достижений. Наверняка многие из вас, кто читает наш сайт, слышали о большинстве из представленных в сегодняшнем списке пунктах. Однако их значимость настолько высока, что очередной раз хотя бы кратко не напомнить о них было бы...
Ooho — дешёвая и съедобная альтернатива пластиковой упаковке
Лондонский стартап Skipping Rocks Lab разработал упаковку будущего, которая может стать отличной заменой пластиковых стаканчиков, пакетов и бутылок. Ooho — безвкусная, но съедобная обёртка, созданная из экстракта морских водорослей. Она прочная, дешёвая в производстве, а главное совершенно эко...
Регенерация частей тела — наше будущее
Кишечнодышащие черви обладают невероятной способностью к регенерации. У людей и этих червей много общих генов, поэтому ученые изучают последних в надежде когда-нибудь стимулировать регенерацию и у людей. Способность к регенерации частей тела всегда была увлекательной перспективой, вдохновляющей таки...